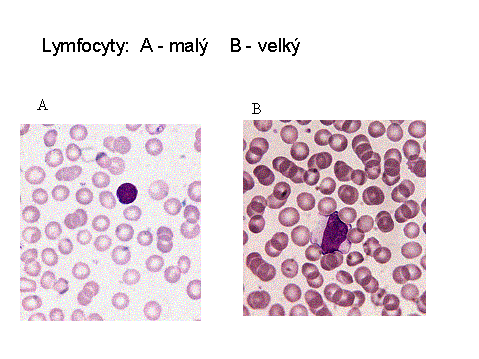

Abstrakt
Lymfocyty jsou zralé buňky bílé krevní řady o průměru 8-12
µm, jádro je poměrně kulaté, oválné nebo na jedné straně vpáčené. Od plazmy je
jasně ohraničeno, nebývá uloženo přesně ve středu. Chromatin jádra je hutný a
bohatý, cytoplazma je světle modrá, někdy až bezbarvá. Lymfocyty, které se
tvoří v kostní dřeni z mateřských lymfoidních kmenových buněk a
vyzrávají zde, se nazývají B-lymfocyty a jsou zodpovědné za specifickou
protilátkovou imunitu. Ty buňky, které přestupují do thymu, zde zrají
v T-lymfocyty a jsou zodpovědné za specifickou buněčnou imunitu. Jsou
zastoupené v kostní dřeni v obvodové krvi.
Odkazy na jiné
relevantní dokumenty, další informace
Popis zralých periferních krevních buněk
Autorské poznámky
Ilona Fátorová, Eva Fenclová